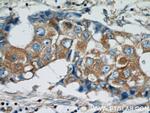
HARS2 Antibody in Immunohistochemistry (Paraffin) (IHC (P))
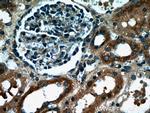
HARS2 Antibody in Immunohistochemistry (Paraffin) (IHC (P))
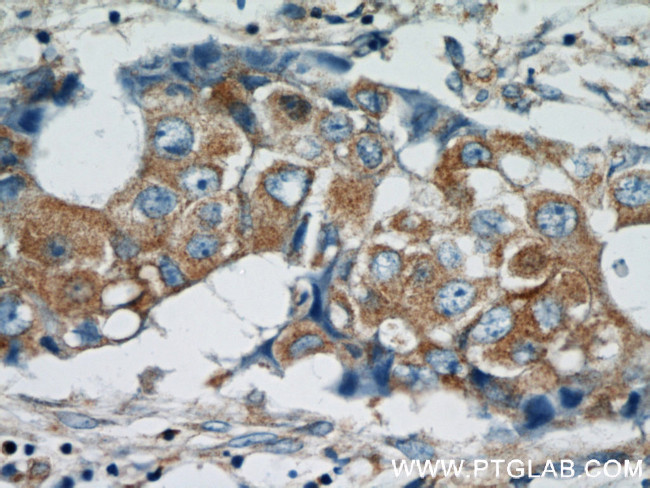
HARS2 Antibody in Immunohistochemistry (Paraffin) (IHC (P))

Search
Proteintech
HARS2 Polyclonal Antibody
{{$productOrderCtrl.translations['antibody.pdp.commerceCard.promotion.promotions']}}
{{$productOrderCtrl.translations['antibody.pdp.commerceCard.promotion.viewpromo']}}
{{$productOrderCtrl.translations['antibody.pdp.commerceCard.promotion.promocode']}}: {{promo.promoCode}} {{promo.promoTitle}} {{promo.promoDescription}}. {{$productOrderCtrl.translations['antibody.pdp.commerceCard.promotion.learnmore']}}

Please note: We are reviewing Western blot images included in the antibody testing data in our catalog, including those provided by third parties. Unless expressly labeled or annotated as “raw-unedited”, Western blot images included in the antibody testing data in our catalog may have been edited, optimized or otherwise adjusted for presentation.
Product Details
11301-1-AP
Species Reactivity
Host/Isotype
Class
Type
Immunogen
Conjugate
Form
Concentration
Amount
Purification
Storage buffer
Contains
Storage conditions
Shipping conditions
Product Specific Information
This antibody can bind both HARSs for the close sequences.
Immunogen sequence: WRRESPTIV QGRYREFCQC DFDIAGQFDP MIPDAECLKI MCEILSGLQL GDFLIKVNDR RIVDGMFAVC GVPESKFRAI CSSIDKLDKM AWKDVRHEMV VKKGLAPEVA DRIGDYVQCH GGVSLVEQMF QDPRLSQNKQ ALEGLGDLKL LFEYLTLFGI ADKISFDLSL ARGLDYYTGV IYEAVLLQTP TQAGEEPLNV GSVAAGGRYD GLVGMFDPKG HKVPCVGLSI GVERIFYIVE QRMKTKGEKV RTTETQVFVA TPQKNFLQER LKLIAELWDS GIKAEMLYKN NPKLLTQLHY CESTGIPLVV IIGEQELKEG VIKIRSVASR EEVAIKRENF VAEIQKRLSE S (157-506 aa encoded by BC014982)
Target Information
Aminoacyl-tRNA synthetases are a class of enzymes that charge tRNAs with their cognate amino acids. The protein encoded by this gene is an enzyme belonging to the class II family of aminoacyl-tRNA synthetases. Functioning in the synthesis of histidyl-transfer RNA, the enzyme plays an accessory role in the regulation of protein biosynthesis. The gene is located in a head-to-head orientation with HARS on chromosome five, where the homologous genes likely share a bidirectional promoter. Mutations in this gene are associated with the pathogenesis of Perrault syndrome, which involves ovarian dysgenesis and sensorineural hearing loss. Alternative splicing results in multiple transcript variants of this gene.
For Research Use Only. Not for use in diagnostic procedures. Not for resale without express authorization.
Bioinformatics
Protein Aliases: EC 6.1.1.21; HisRS; Histidine--tRNA ligase, mitochondrial; Histidine--tRNA ligase-like; Histidyl-tRNA synthetase; histidyl-tRNA synthetase 2, mitochondrial (putative); probable histidine--tRNA ligase, mitochondrial; zinc finger, matrin type 2
Gene Aliases: 4631412B19Rik; Hars2; Hars2l; Harsl; HARSR; HO3; RGD1308426; Zmat2
UniProt ID: (Mouse) Q99KK9
Entrez Gene ID: (Rat) 307491, (Mouse) 70791

Performance Guarantee
If an Invitrogen™ antibody doesn't perform as described on our website or datasheet,we'll replace the product at no cost to you, or provide you with a credit for a future purchase.*
Learn more
We're here to help
Get expert recommendations for common problems or connect directly with an on staff expert for technical assistance related to applications, equipment and general product use.
Contact tech support